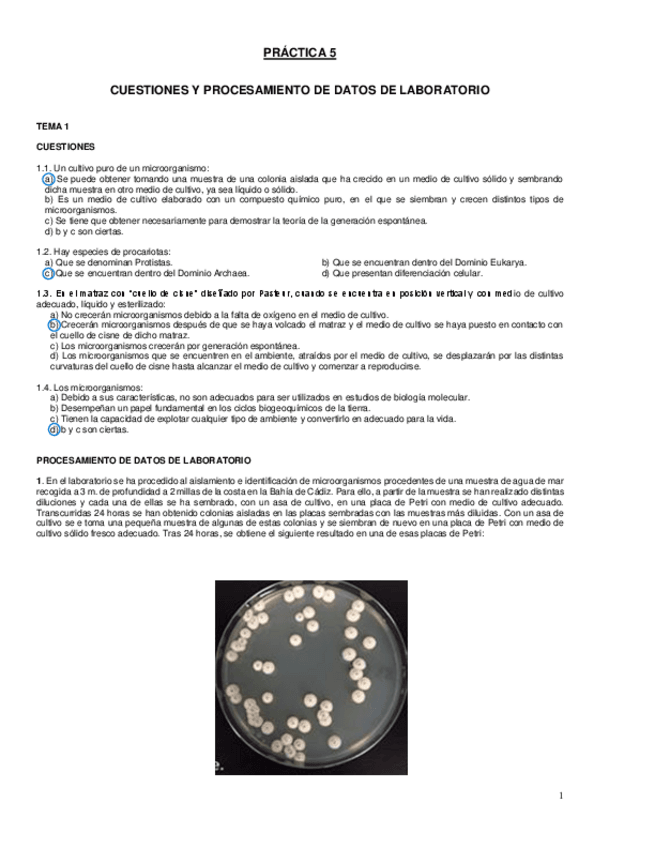

Microbiología
apuntes
-
RECOPILACIÓN PREGUNTAS TIPO TEST TODOS LOS TEMAS
Preguntas de examen de TODOS LOS TEMAS con explicación MUY COMPLETO
He publicado nuevos apuntes de 1º Microbiología: Esquema-de-como-se-organizan-las-celul.pdf
apuntes
-
temas microbiología
He publicado nuevos apuntes de 1º Microbiología: temas microbiología
He publicado nuevos practicas de 1º Microbiología: Practicas-finales-microbiologia.pdf
apuntes
-
resumenes clave para el examen
He publicado nuevos apuntes de 1º Microbiología: resumenes clave para el examen
apuntes
-
apuntes micro
He publicado nuevos apuntes de 1º Microbiología: apuntes micro
He publicado nuevos apuntes de 1º Microbiología: TEMA-15-MICROBIOLOGIA.pdf
He publicado nuevos apuntes de 1º Microbiología: TEMA-14-MICROBIOLOGIA.pdf
He publicado nuevos apuntes de 1º Microbiología: TEMA-13-MICROBIOLOGIA.pdf
He publicado nuevos apuntes de 1º Microbiología: TEMA-12-MICROBIOLOGIA.pdf
He publicado nuevos apuntes de 1º Microbiología: TEMA-11-MICROBIOLOGIA-ecologia-microbiana.pdf
He publicado nuevos apuntes de 1º Microbiología: TEMA-10-MICROBIOLOGIA.pdf
He publicado nuevos apuntes de 1º Microbiología: TEMA-9-MICROBIOLOGIA-metabolismo.pdf
He publicado nuevos apuntes de 1º Microbiología: TEMA-8-MICROBIOLOGIA.pdf
He publicado nuevos apuntes de 1º Microbiología: TEMA-7-MICROBIOLOGIA-genetica-microbiana.pdf
He publicado nuevos apuntes de 1º Microbiología: TEMA-6-MICROBIOLOGIA-virus.pdf
He publicado nuevos apuntes de 1º Microbiología: TEMA-5-MICROBIOLOGIA-protistas.pdf
He publicado nuevos apuntes de 1º Microbiología: TEMA-4-MICROBIOLOGIA-morfologia.pdf
He publicado nuevos apuntes de 1º Microbiología: TEMA-3-MICROBIOLOGIA.pdf
He publicado nuevos apuntes de 1º Microbiología: TEMA-2-MICROBIOLOGIA.pdf
He publicado nuevos apuntes de 1º Microbiología: TEMA-1-MICROBIOLOGIA.pdf
apuntes
-
temario completo microbiología
He publicado nuevos apuntes de 1º Microbiología: temario completo microbiología
He publicado nuevos apuntes de 1º Microbiología: 1o-MICROBIOLOGIA-TEMA-15-ATENUACION-MICROBIANA-DE-LA-CONTAMINACION.pdf
He publicado nuevos apuntes de 1º Microbiología: 1o-MICROBIOLOGIA-TEMA-14-MICROORG-INDICADORES-DE-CONTAMINACION-MARINA.pdf
He publicado nuevos apuntes de 1º Microbiología: 1o-MICROBIOLOGIA-TEMA-TEMA-13-INTERACCIONES-MICROORGANISMOS-Y-ORGANISMOS-II.pdf
He publicado nuevos apuntes de 1º Microbiología: 1o-MICROBIOLOGIA-TEMA-12-INTERACCIONES-ENTRE-MICROORGANISMOS.pdf
He publicado nuevos apuntes de 1º Microbiología: 1o-MICROBIOLOGIA-TEMA-11-FUNDAMENTOS-DE-LA-ECOLOGIA-MICROBIANA.pdf
He publicado nuevos apuntes de 1º Microbiología: 1o-MICROBIOLOGIA-TEMA-10-CRECIMIENTO-MICROBIANO.pdf
He publicado nuevos apuntes de 1º Microbiología: 1o-MICROBIOLOGIA-TEMA-9-METABOLISMOS-MICROBIANOS.pdf
He publicado nuevos apuntes de 1º Microbiología: 1o-MICROBIOLOGIA-TEMA-8-TAXONOMIA-CLASIFICACION-MICROBIANA.pdf
He publicado nuevos apuntes de 1º Microbiología: 1o-MICROBIOLOGIA-TEMA-7-GENERALIDADES-EN-LA-GENETICA-MICROBIANA.pdf
He publicado nuevos apuntes de 1º Microbiología: 1o-MICROBIOLOGIA-TEMA-6-CARACTERISTICAS-GENERALES-DE-LOS-VIRUS.pdf
He publicado nuevos apuntes de 1º Microbiología: 1o-MICROBIOLOGIA-TEMA-5-MORFOLOGIA-TAMANO-Y-ESTRUCTURA-MICROBIANA-II.pdf
He publicado nuevos apuntes de 1º Microbiología: 1o-MICROBIOLOGIA-TEMA-1-LA-CIENCIA-DE-LA-MICROBIOLOGIA.pdf
He publicado nuevos apuntes de 1º Microbiología: 1o-MICROBIOLOGIA-TEMA-2-METODOS-EN-LA-MICROBIOLOGIA-I.pdf
He publicado nuevos apuntes de 1º Microbiología: 1o-MICROBIOLOGIA-TEMA-3-METODOS-EN-LA-MICROBIOLOGIA-II.pdf
He publicado nuevos apuntes de 1º Microbiología: 1o-MICROBIOLOGIA-TEMA-4-MORFOLOGIA-TAMANO-Y-ESTRUCTURA-MICROBIANA-I.pdf
apuntes
-
Microbiología.
He publicado nuevos apuntes de 1º Microbiología: Microbiología.
He publicado nuevos practicas de 1º Microbiología: Cuestionarios-Practicas-Microbiologia.pdf
apuntes
-
Apuntes Microbiología
He publicado nuevos apuntes de 1º Microbiología: Apuntes Microbiología